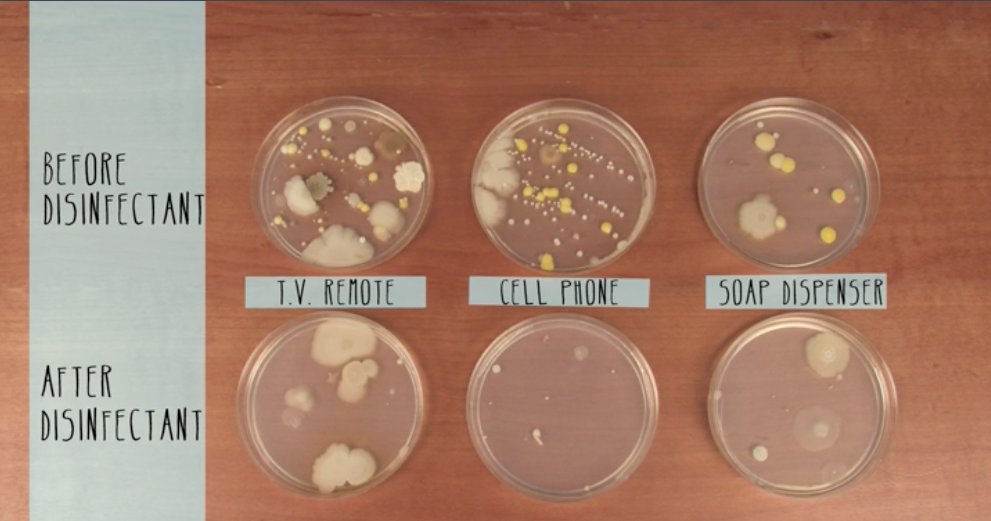

ಟ್ವೀಟ್ಗಳು
- ಟ್ವೀಟ್ಗಳು
- ಟ್ವೀಟ್ಗಳು & ಪ್ರತಿಕ್ರಿಯೆಗಳು
- ಮಾಧ್ಯಮ
@SteveSpangler ತಡೆಹಿಡಿಯಲಾಗಿದೆ
ನೀವು ಖಚಿತವಾಗಿಯೂ ಈ ಟ್ವೀಟ್ಗಳನ್ನು ನೋಡಲು ಬಯಸುವಿರಾ? ಟ್ವೀಟ್ಗಳನ್ನು ನೋಡುವುದು @SteveSpangler ಅವರನ್ನು ತಡೆತೆರವುಗೊಳಿಸುವುದಿಲ್ಲ.
-
Backstage at
@foxandfriends getting science demos ready for@SteveDoocy@ainsleyearhardt@kilmeade @adamkoltzfnc#sciencefunpic.twitter.com/U503QqGguh
-
Looking forward to more science fun on
@foxandfriendshttps://twitter.com/foxandfriends/status/833630734141181952 … 0:32
0:32 -
Here's what happens when you mix hydrogen and oxygen for a science segment on
@foxandfriends ...pic.twitter.com/FMjTfEheg9 -
.
@ClaytonMorris Here's your amazing hero shotpic.twitter.com/P9P5R64AW8
-
The amazing
@ClaytonMorris knocks the eggs into the glasses like a science guy pro. Having a blast on@foxandfriends#eggdroppic.twitter.com/pfO156kp6K


-
Always fun turning on TV and seeing my rock star pal
@SteveSpangler doing mad science on Fox & Friends. -
Backstage at
@foxandfriends getting ready for some fun science demos. Cover your ears.#scienceontvpic.twitter.com/hspmVLaJyX

-
Join me on
@foxandfriends tomorrow morning for some science fun... a few kabooms... and a little mess.#cleanupatFOXpic.twitter.com/z9FNXXlcut
-
Producers at
@NBCLilBigShots called an asked to feature our messiest science demo from last season on@TheEllenShow. Thanks!#nitrogencloudpic.twitter.com/GZCFrw1pFI -
The wife of a science guy gets different kinds of flowers. Celebrating Valentine's Day at
@9NEWSpic.twitter.com/0llYmZ2fb6


-
Freezing flowers
@9NEWS and crushing them on (I mean with)@CoreyRoseTV@ChristineNoelTV and@GaryShapiro#ValentinesDaySciencepic.twitter.com/fxnUM5sf4v -
Best part of Mondays at
@9NEWS with@Belen_DeLeon and a box of science tricks.#DontLightBelenOnFirepic.twitter.com/fQOTkQGUWn
-
Look at the bacteria growing on the top of a soap dispenser! It's science project time
@9NEWS today with some surprises for@Kim9news.pic.twitter.com/Wb5y5pnung
-
-
How to make things float on National Static Electricity Day on
@9NEWS. Or how to shock@Kim9news by accident, of course.pic.twitter.com/KsMKuRCPma
-
Love making those
#nakedeggs and hanging out at@THEMUSEUMhttps://twitter.com/themuseum/status/810996884785524736 …
-
We did a
@stevespangler science kit last night that included watching the "m" float off the M&M! Pretty cool!#fourthgradefun#stevespanglerpic.twitter.com/nOagFt4BNp
-
Walking on glass with
@CherylPreheim and@CoreyRoseTV and the#footcam on@9NEWS Exploring the science of pressure.pic.twitter.com/FwQSjqZPkL -
Nothing says happy holidays like making
@CoreyRoseTV and@CherylPreheim walk on glass at@9NEWSpic.twitter.com/V8zBQVHXR3
-
Let's find a way to collaborate. Still on the road for another week but would love to connect later in December or after the first of the...
ಲೋಡಿಂಗ್ ಸಮಯ ಸ್ವಲ್ಪ ತೆಗೆದುಕೊಳ್ಳುತ್ತಿರುವಂತೆನಿಸುತ್ತದೆ.
Twitter ಸಾಮರ್ಥ್ಯ ಮೀರಿರಬಹುದು ಅಥವಾ ಕ್ಷಣಿಕವಾದ ತೊಂದರೆಯನ್ನು ಅನುಭವಿಸುತ್ತಿರಬಹುದು. ಮತ್ತೆ ಪ್ರಯತ್ನಿಸಿ ಅಥವಾ ಹೆಚ್ಚಿನ ಮಾಹಿತಿಗೆ Twitter ಸ್ಥಿತಿಗೆ ಭೇಟಿ ನೀಡಿ.


 Steve Spangler
Steve Spangler
 Mark Sanborn
Mark Sanborn

 Hayley Reed
Hayley Reed